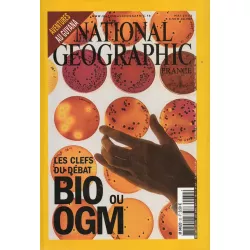

Menu
National Geographic
2,00 €
TTC
Collectif
Mai 2002
Dossier : Bio ou OGM, les clefs du débat.
| Auteur | Collectif |
|---|---|
| Etat | Etat : Très bon état |
Très bon état. De légères marques. Livre broché.
Livraison
Livraison standard
...
Livraison express en 2 jours
...
Retours
Retour au magasin
...
Vous aimerez aussi
5,00 €
| Auteur | Collectif |
|---|---|
| Etat | Etat : Très bon état |
Revues
Previous
Next